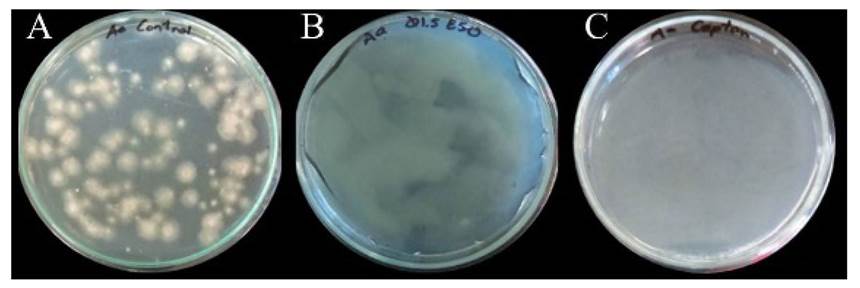

México es uno de los diez países a nivel mundial con mayor producción de jitomate (Solanum lycopersicum), el cultivo en México satisface la demanda interna y se exporta aproximadamente el 46% de la cosecha (FAO, 2016). Diversos microorganismos fitopatógenos pueden ocasionar enfermedades en el cultivo de jitomate, principalmente los hongos (Orberá et al., 2014). Los géneros que ocasionan las mayores pérdidas en pre y poscosecha son Alternaria, Botrytis, Penicillium, Colletotrichum y Rhizopus (Petriacq, 2018; Trigos et al., 2008). Las afectaciones que provocan son variadas, desde síntomas poco visibles hasta devastaciones completas de áreas de cultivo (Dean et al., 2012; Strange y Scott, 2005). Los daños por Alternaria son comunes alrededor del mundo, se caracterizan por la aparición de manchas negras y marchitez, que afectan hojas, tallos, flores y frutos (Agrios, 1997; Logrieco et al., 2009). Los fungicidas de origen sintético son las principales herramientas para el control y manejo de enfermedades en plantas; sin embargo, el uso excesivo genera problemas importantes en la salud y medio ambiente. Por lo que existe una exigencia de manejo de cultivos y alimentos libres de agroquímicos por parte de los consumidores (Sánchez-Bayo y Tennekes, 2015).
Una alternativa para la reducción de agroquímicos es el uso de biopolímeros como el quitosano, el cual es un compuesto abundante en la naturaleza, que se obtiene por la desacetilación parcial de la quitina (componente principal del exoesqueleto de artrópodos) a través de un tratamiento térmico alcalino, tiene propiedades de biodegradabilidad, inocuidad y actividad antifúngica que lo hacen un producto ideal y de fácil manejo (Waewthongrak et al., 2015). Diversos autores reportan que este biopolímero controla enfermedades causadas por hongos fitopatógenos en cultivos de papaya (Carica papaya), tomate (Physalis ixocarpa), plátano (Musa × paradisiaca) y otros (Bautista-Baños et al., 2003; De Oliveira et al., 2016; Liu et al., 2007; Maqbool et al., 2010). Además, tiene la capacidad de formar películas o recubrimientos y sirve como matriz para incorporar otros aditivos o componentes que pueden añadir o potenciar alguna propiedad (Zargar et al., 2015).
En este sentido, el quitosano es una opción para mezclarse con otros agentes antifúngicos, tales como metabolitos secundarios, como los presentes en los extractos libres de células de Pseudomonas fluorescens. Esta bacteria muestra efectos de control frente a hongos fitopatógenos en los cultivos de col (Brassica oleracea), alfalfa (Medicago sativa), trigo (Triticum aestivum), haba (Vicia faba) y otros (Alemu y Alemu, 2013; Mishra y Arora, 2012; Yanes et al., 2012;), mediante la producción de metabolitos extracelulares, que pueden recuperarse del medio de cultivo y ejercen un efecto antifúngico sin la necesidad de tener la bacteria presente (Pal y McSpadden, 2006) y abordar las limitaciones del uso de biomasa. El objetivo de este estudio fue evaluar el efecto antifúngico de la combinación de quitosano y extractos de P. fluorescens en el control in vitro de micelio y conidios de A. alternata; así como, la incidencia y severidad en plantas de jitomate en invernadero, como una posible alternativa para reducir el uso de agroquímicos.
Materiales y métodos
Material biológico. La bacteria Pseudomonas fluorescens se aisló de la rizosfera microbiana de estolones de fresa (Fragaria sp.) de la localidad del Ejido de la Finca, Villa Guerrero, Estado de México (18° 53’ 07” N, 99° 37’ 36” O y altitud de 1839 msnm) durante el ciclo productivo 2012-2013. La bacteria se purificó e identificó a nivel género de acuerdo con la metodología propuesta por Schaad (1988). Se realizó la caracterización molecular por amplificación y secuenciación del rARN 16s y alineación con las bases de datos del Banco de Genes del Centro Nacional para la Información Biotecnológica (NCBI, por sus siglas en inglés).
El hongo fitopatógeno Alternaria alternata se aisló de frutos de jitomate con síntomas característicos de la enfermedad, se identificó y caracterizó molecularmente en el Laboratorio de Fisiología Postcosecha del Centro de Desarrollo de Productos Bióticos del Instituto Politécnico Nacional, se cultivó en medio Papa Dextrosa Agar (PDA, BD Bioxon, México) durante 4-7 días e incubó a temperatura ambiente (25 ± 2 °C) para los ensayos posteriores.
Para los experimentos en invernadero, se utilizaron plantas de jitomate de la variedad Saladett (Eterno F1) en la etapa vegetativa (de 15 a 25 cm de altura) hasta la floración, obtenidas de siembra directa en pellets de peatmoss y cultivadas en macetas de 5 L aproximadamente, en una mezcla de tierra orgánica-peatmoss-agrolita en proporción 4:1:1, en invernadero (32 °C, 75% HR, aproximadamente) de febrero a junio de 2017.
Preparación de quitosano y extractos de P. fluorescens . La solución de quitosano (Qs) (Sigma Aldrich, EUA) se preparó al 3% (p/v) y se obtuvo al disolver 3.0 g de quitosano de bajo peso molecular (50-190 kDa, 85% desacetilación) en 100 mL de agua destilada, se añadió lentamente ácido acético glacial (Fermont, México) al 1% (v/v). La solución se agitó y calentó a 40 °C durante 24 h, el pH se ajustó a 5.6 con hidróxido de sodio 1 N y se esterilizó por 15 min a 15 psi. El extracto de P. fluorescens (EPf) se obtuvo al cultivar la bacteria en medio B de King (25 ± 2 °C, 72 h, 120 rpm), se centrifugó 15 min a 10015 xg, el sobrenadante se filtró con membranas estériles (Cole Palmer, EUA) de 0.22 µm para retener la biomasa celular remanente.
Pruebas de control in vitro de A. alternata: crecimiento micelial y germinación de conidios. Para las pruebas de inhibición del crecimiento micelial se realizó un diseño de tratamientos en arreglo factorial, los factores y niveles fueron Qs [0, 0.5, 1.0, y 1.5% (p/v)] y EPf [0, 15, 30 y 50% (v/v)] con seis repeticiones por tratamiento. Se incluyó Captan (0.25% p/v) como control positivo. El pH de todos los tratamientos se ajustó a 5.6. La unidad experimental fue una caja Petri (90 x 15 mm) con medio de cultivo PDA, se depositó y distribuyó de manera uniforme sobre la superficie del medio 0.5 mL de cada uno de los tratamientos y se dejó secar de 5 a 10 min. Después se colocaron en el centro de la caja discos (5 mm de diámetro) de PDA con micelio del hongo e incubaron a temperatura ambiente. El tiempo límite de incubación se determinó cuando el crecimiento micelial del control negativo (Qs 0% + Epf 0%) alcanzó el borde de la caja. Para cada unidad experimental se midió y promedió el diámetro de la colonia en dos direcciones. El porcentaje de inhibición micelial se calculó según Korsten y Jager (1995) con la fórmula: Inhibición (%) = [(DC - DT) / DC) x 100]; donde DC es el diámetro del cultivo control, y DT el diámetro del cultivo del tratamiento.
Para la prueba de germinación de conidios se utilizó la mezcla que presentó la mayor inhibición micelial in vitro (%) estadísticamente significativa *=p ≤ 0.05. Se incluyeron agua destilada como control negativo y Captan (0.25% p/v) como control positivo, con 6 repeticiones para cada tratamiento. Se depositó 0.5 mL de cada tratamiento sobre la superficie de las cajas Petri con PDA, se distribuyó de manera uniforme, se dejó secar de 5 a 10 min, se inoculó con una suspensión (0.1 mL) de conidios (106 mL-1) e incubó a 25 ± 2°C durante 4 días y se determinó el porcentaje de germinación de conidios.
Pruebas de control de A. alternata en plantas de jitomate en invernadero. Para la prueba en invernadero se utilizó la mezcla que presentó la mayor inhibición micelial in vitro (%) estadísticamente significativa *=p ≤ 0.05. Se incluyeron agua destilada como control negativo y Captan (0.25 % p/v) como control positivo, con 15 repeticiones para cada tratamiento. Las plantas se colocaron en cámaras húmedas 24 h antes de la inoculación por aspersión con una suspensión de conidios (106 mL-1). Las plantas inoculadas se incubaron 72 h en cámaras húmedas, después se asperjaron los tratamientos y se llevaron a invernadero (32 °C, 75% HR, aproximadamente). Después de la primera aplicación, los tratamientos se asperjaron cada 7 días hasta la floración y se evaluó la incidencia como la fracción de unidades experimentales por tratamiento con síntomas (tizón de hojas, clorosis, defoliación o marchitez) y la severidad de la enfermedad como la fracción de hojas dañadas respecto al total de hojas de cada unidad experimental por cada tratamiento (Terna et al., 2016). Las evaluaciones se realizaron 7, 30 y 60 días después de la inoculación (DDI).
Análisis de datos. Para los tratamientos in vitro y en invernadero se utilizó un diseño completamente al azar y se analizaron por medio de un ANDEVA, los tratamientos se compararon con la prueba Tukey (*=p ≤ 0.05). Antes del análisis, los datos de severidad en porcentaje se transformaron con logaritmo [log (x + 1)]. Estos análisis se realizaron con SAS® 9.4.
Resultados y discusión
Material biológico. La bacteria P. fluorescens aislada en estolones de fresa fue Gram negativa, en el medio de crecimiento específico levadura-dextrosa-carbonato de calcio (YDC) las colonias mostraron coloración crema-blanco después de 48 h de incubación; en agar B de King (KB), después de 48 h de incubación, las colonias produjeron un pigmento amarillo que rodeó la colonia y que bajo condiciones de luz ultravioleta fue verde-amarillo fluorescente (Figura 1). Las colonias blancas en YDC pueden corresponder a los géneros Pseudomonas, Erwinia o Agrobacterium, mientras que la pigmentación y fluorescencia en agar B de King es característico de P. fluorescens (Schaad, 1988).

Figura 1 Características culturales de P. fluorescens. Colonias en medio YDC (A), pigmento amarillo en agar King B (B), y fluorescencia bajo luz UV (C).
El resultado de la caracterización cultural se corroboró con la caracterización molecular (Cuadro 1) mediante el análisis del gen 16s y el alineamiento de la secuencia de los pares de bases (pb) con las del Banco de Genes del NCBI. El ADN tuvo un peso molecular de 425 pb, la secuencia se alineó en primer, segundo y tercer lugar respectivamente con Pseudomonas lutea (Número de acceso NZ_JRMB01000004.1, NZ_JRMB01000003.1 y NZ_JRMB01000002.1, Kwak et al., 2016), con un índice de similaridad del 99% y 467 pb para todas las secuencias, la diferencia fue de dos nucleótidos (NZ_JRMB01000004.1) y tres nucleótidos (NZ_JRMB01000003.1, NZ_JRMB01000002.1) y puntuaciones máximas de 774, 769 y 769 respectivamente de una puntuación total de 774. En séptimo lugar se alineó con P. fluorescens (Número de acceso NR113647, Redondo et al., 2012) con un valor de 763 y un índice de 99 %, con una diferencia de cuatro nucleótidos, ambas secuencias con 425 pb. Las diferencias entre nucleótidos de P. fluorescens y la secuencia de estudio se encuentran distribuidas de manera aleatoria a lo largo de toda la secuencia, a diferencia de P. lutea, donde las diferencias se localizan en los mismos codones para las tres secuencias; la diferencia de los nucleótidos y pares de bases entre la secuencia de estudio y P. lutea indica diferencias moleculares que caracterizan a cada especie, mientras que las diferencias entre P. fluorescens y la secuencia de estudio puede deberse a polimorfismos por sustitución de pares de bases, atribuibles a una posible mutación; con base a la alta homología molecular y la caracterización cultural, se concluye que el agente de biocontrol fue P. fluorescens.
Cuadro 1 Secuencia de pares de bases de P. fluorescens aislada en Villa Guerrero, Estado de México
| CCGGGAACGTATTCACCGCGACATTCTGATTCGCGATTACTAGCGATTCCGACTTCACGCAGTCGAGTTGCAGACTGCGATCCGGACTACGATCGGTTTTATGGGATTAGCTCCACCTCGCGGCTTGGCAACCCTTTGTACCGACCATTGTAGCACGTGTGTAGCCCAGGCCGTAAGGGCCATGATGACTTGACGTCATCCCCACCTTCCTCCGGTTTGTCACCGGCAGTCTCCTTAGAGTGCCCACCATAACGTGCTGGTAACTAAGGACAAGGGTTGCGCTCGTTACGGGACTTAACCCAACATCTCACGACACGAGCTGACGACAGCCATGCAGCACCTGTCTCAATGTTCCCGAAGGCACCAATCCATCTCTGGAAAGTTCATTGGATGTCAAGGCCTGGTAAGGTTCTTCGCGTTGCTTC |
Pruebas de control in vitro de A. alternata: crecimiento micelial y germinación de conidios. El crecimiento radial en el control negativo de A. alternata en medio PDA cubrió el 100% de la caja de Petri después de 26 días de incubación. Todos los tratamientos tuvieron una reducción en el crecimiento micelial estadísticamente significativo (*=p≤0.05) con respecto al control negativo, así como un efecto inhibitorio (Cuadro 2, Figura 2).
En los tratamientos que contenían únicamente Qs, el crecimiento micelial de A. alternata se inhibió entre 9 y 33%, sin embargo, en otros estudios el efecto inhibitorio se observó con concentraciones desde 0.5% de quitosano y mayores a las reportadas en el presente trabajo, con una inhibición del 54.6% para Fusarium solani f.sp. glycines (Prapagdee et al., 2007) y del 100% para Botrytis cinerea (Liu et al., 2007) y Alternata chikunkiana (Meng et al., 2008).
Cuadro 2 Crecimiento micelial e inhibición (%) in vitro de las mezclas de quitosano y extractos de P. fluorescens sobre A. alternata.
| Tratamiento (Qs % + EPf %) | Crecimiento de A. alternata (mm) | Inhibición (%) de A. alternata |
|---|---|---|
| Captan (0.25 % p/v) x | 24.8 h | 70.8 h |
| Qs 0.0 + EPf 0.0 y | 85.0 a | 0.0 a |
| Qs 0.5 + EPf 0.0 | 77.2 b | 9.2 b |
| Qs 1.0 + EPf 0.0 | 75.6 b | 11.0 b |
| Qs 1.5 + EPf 0.0 | 56.8 c | 33.2 c |
| Qs 0.0 + EPf 15 | 55.1 c | 35.2 c |
| Qs 0.0 + EPf 30 | 46.3 d | 45.5 d |
| Qs 0.0 + EPf 50 | 44.4 d e | 48.8d e |
| Qs 0.5 + EPf 15 | 52.7 c | 38.0 c |
| Qs 0.5 + EPf 30 | 43.5 d e | 48.8 d e |
| Qs 0.5 + EPf 50 | 39.6 e f | 54.9 e f |
| Qs 1.0 + EPf 15 | 43.8 d e | 48.5d e |
| Qs 1.0 + EPf 30 | 41.6 d e f | 51.0 d e f |
| Qs 1.0 + EPf 50 | 38.3 f g | 56.9 f g |
| Qs 1.5 + EPf 15 | 44.4 d | 47.8 d |
| Qs 1.5 + EPf 30 | 39.6 e f | 53.4 e f |
| Qs 1.5 + EPf 50 | 33.8 g | 60.2 g |
x Control positivo. y Control negativo. Medias con distinta letra son estadísticamente diferentes (Tukey *=p≤0.05)
/ x Positive control. y Negative control. Means with different letters are statistically different (Tukey’s Test *=p≤0.05).

Figura 2 Efecto de control in vitro de las mezclas de quitosano y extractos de P. fluorescens (Qs % + Epf %) sobre A. alter nata.
Por otro lado, el efecto antifúngico individual de los EPf fue mayor que la del Qs en todos los casos, con una inhibición máxima del 47 %; en comparación con otros extractos celulares, los extractos de Streptomyces griseus redujeron un 33 % el desarrollo in vitro de Fusarium oxysporum f. sp. cubense (Zacky y Ting, 2013) y extractos de Bacillus subtilis inhibieron un 94% el desarrollo micelial in vitro de Penicillium digitatum (Waewthongrak et al., 2015).
Las mezclas de Qs y EPf tuvieron mayor inhibición en comparación con los efectos individuales en todos los casos, la mezcla con la mayor concentración de ambos componentes (Qs 1.5 % + EPf 50%) tuvo el mayor efecto de control en el crecimiento micelial de A. alternata; ya se reportó el efecto de la mezcla de quitosano y otros compuestos antifúngicos para el control de hongos fitopatógenos, la mezcla de quitosano con cera de abeja y aceite esencial de limón inhibe el 100% el crecimiento micelial de Rhizopus stolonifer (Ramos-García et al., 2012), la mezcla de quitosano con etanol (Qs 0.5% + etanol 20%) redujo hasta 94% el deterioro por B. cinerea en uva (Romanazzi et al., 2007), la mezcla de quitosano con extractos de hojas de papaya y chirimoya redujeron el crecimiento micelial de Colletotrichum gloeosporoides hasta 50% con respecto al control (Bautista-Baños et al., 2003).
La mayor inhibición del crecimiento micelial de este estudio (60.2%) fue menor respecto a ensayos anteriores, en donde los agentes antifúngicos se mezclaron con el sustrato (PDA) como un medio envenenado; para este trabajo, se aplicó como recubrimiento en la superficie del medio de cultivo, que simula las condiciones de aplicaciones in vivo en donde los agentes de biocontrol se asperjan sobre la superficie de hojas y frutos (Feliziani et al., 2015; Saavedra et al., 2016). La mezcla de Qs 1.5% + EPf 50% se utilizó para evaluar la germinación de conidios y tuvo un efecto inhibitorio de 100 %, igual al efecto del fungicida comercial, en comparación con el control negativo, después de 4 días de aplicar los tratamientos (Figura 3).
El efecto de control de la mezcla Qs 1.5% + EPf 50%, se relaciona con la capacidad antifúngica de los componentes. La naturaleza policatiónica del quitosano interfiere con las cargas negativas de la membrana celular, modifica la permeabilidad y provoca la fuga del material intracelular, así como la separación entre membrana y pared celular de hifas y conidios (Bautista-Baños et al., 2016; Sánchez-Domínguez et al., 2011). El adelgazamiento de hifas y perdida del contenido citoplasmático se debe al aumento en la permeabilidad de la membrana, inducida por la interacción electrostática de los grupos amino del quitosano con las cargas negativas de la membrana (Palma et al., 2008).
Figura 3 Germinación de conidios de Alternaria alternata en PDA; control negativo (A), mezcla de Qs 1.5% + EPf 50% (B), Captan 0.25% p/v (C).
El uso de extractos de P. fluorescens (Epf) representa una interesante opción para abordar las limitaciones del uso de biomasa celular. Comúnmente P. fluorescens se usa como agente de biocontrol mediante la aplicación de células viables en el suelo o plantas, con resultados variables debido a la falta de viabilidad a largo plazo e incapacidad para producir estructuras especializadas de resistencia (endosporas) como otros géneros de biocontrol (Narayasamy, 2003). Adicionalmente la inoculación es inconsistente de un campo de cultivo a otro y de un año a otro, debido a la variabilidad en la colonización que resulta en una expresión variable de los mecanismos de biocontrol como antibióticos (Mark et al., 2006). Otra limitante del uso de P. fluorescens es el impacto ecológico en las poblaciones saprofitas indígenas, con efectos negativos sobre la rizosfera (Couillerot et al., 2008). Además, existe la posible transferencia a antibióticos (Nwosu, 2001) a otras bacterias, ya que se ha documentado la transferencia de plásmidos entre cepas introducidas e indígenas de bacterias del suelo (Daane et al., 1996). El uso de los extractos producidos por P. fluorescens (Epf) de este estudio demuestra el efecto antifúngico in vitro, como una alternativa viable para el control de A. alternata.
En los extractos de P. fluorescens del presente estudio, no se determinaron las identidades de los compuestos antifúngicos, pero el control biológico por P. fluorescens se atribuye a la producción de compuestos extracelulares como fenazinas, fluoroglucinoles, pirrolidina, pirrolnitrina, lipopéptidos cíclicos, sideróforos y cianuro de hidrógeno (Gerhardson, 2002; Hass y Defago, 2005). Se ha propuesto que estos compuestos actúan como inhibidores enzimáticos en el metabolismo de la glucosa, que se difunden a través de la membrana, actúan como agentes reductores, producen compuestos tóxicos que afectan la morfología de hifas y conidios y aceleran el proceso de muerte (Chin-A-Woeng et al., 2003; Premachandra et al., 2016).
Pruebas de control de A. alternata en plantas de jitomate en invernadero. La incidencia de la enfermedad causada por A. alternata fue 100%, todas las plantas tratadas mostraron los síntomas característicos, como hojas con manchas circulares de color café obscuro a negro y marchitez. La severidad de la enfermedad mostró variaciones a lo largo de la aplicación de los tratamientos, al final de las aplicaciones se observó un comportamiento sin diferencia estadística entre Qs 1.5% + EPf 50% y Captan (Cuadro 3).
El éxito de un producto de control biológico, depende de la capacidad de control del patógeno, sin embargo alcanzar niveles de efectividad altos (95-98%), mediante el uso de un único agente de biocontrol resulta difícil (Guetsky et al., 2002). Actualmente se busca el uso de mezclas de agentes de biológicos o aditivos para superar el rendimiento variable de los agentes de biocontrol y aumentar la efectividad del control (Droby, 2006). El uso de mezclas de agentes de biocontrol que exhiben varios o distintos mecanismos de acción dará lugar a efectos sinérgicos y en algunos casos antagónicos (Guetsky et al., 2001).
Existen diversos reportes sobre el manejo de las enfermedades causadas por hongos en cultivos de interés alimentario mediante la aplicación de mezclas de quitosano con extractos de microorganismos de biocontrol o células viables de éstos, pero los resultados son variables. Contrario a este estudio, Postma et al., (2009) observaron que una mezcla de extracto de Lysobacter enzymogenes y quitosano (1.0%) no inhibió la enfermedad causada por Pythium aphanidermatum en plantas de pepino, pero la mezcla con biomasa viable redujo en 74% de la incidencia de la enfermedad. Por otro lado, concentraciones a partir de 0.01% de quitosano disminuyen el número de células viables del agente de biocontrol Cryptococcus laurentii (Ting et al., 2012) por lo que una mezcla de ambos agentes no es viable.
Cuadro 3 Efecto de la aplicación de la mezcla Qs 1.5% + EPf 50% en la severidad en plantas de jitomate en invernadero.
| Tratamiento | Severidad (%) | ||
|---|---|---|---|
| 7 DDIx | 30 DDIx | 60 DDIx | |
| Control negativo (agua) | 57.4 a | 36.0 a | 21.3 a |
| Control positivo (Captan) | 38.9 b | 21.0 b | 16.9 b |
| Qs1.5 % + EPf50 % | 51.8 a | 29.8 ab | 16.2 b |
Medias con distinta letra en cada columna son estadísticamente diferentes (Tukey *=p≤0.05) / Means with different letters in each column are statistical different (Tukey´s Test *=p≤0.05).
x DDI (días después de la inoculación) / x DAI (days after inoculation).
La combinación del quitosano en combinación con los extractos de P. fluorecens (Q + Epf) demostró ser efectiva para el control de A alternata. El modo de acción del quitosano puede ser atribuido a un efecto antimicrobiano directo sobre el patógeno o inducción de resistencia de la planta (Bakeer et al., 2016). Por otro lado, el principal mecanismo de acción atribuible a P. fluorecens es la producción de diferentes tipos de antibióticos (Walsh et al., 2001). En el presente estudio la reducción de la severidad de A. alternata podría atribuirse la combinación de los distintos mecanismos de acción de ambos agentes.
Los mejores resultados de inhibición de las enfermedades se obtienen con quitosano en concentraciones superiores a 0.5% (Miranda, 2016), pero los mecanismos de acción que se ejercen sobre los hongos fitopatógenos también podrían inhibir el crecimiento de algunos microrganismos de biocontrol (Xing et al., 2015). Por lo tanto, la mezcla antifúngica de este estudio es una alternativa a este comportamiento, ya que no existe un efecto antagónico del quitosano sobre el inóculo o las células de P. fluorescens y se mantiene el efecto de ambos agentes antifúngicos.
Conclusiones
Los extractos de P. fluorescens, el quitosano y la mezcla de ambos agentes, inhibieron el crecimiento micelial y la germinación de conidios de A. alternata en pruebas in vitro. En las pruebas en invernadero todas las plantas mostraron los síntomas típicos del hongo A. alternata. El efecto antifúngico de las mezclas de quitosano y extractos de P. fluorescens, fue mayor respecto a los agentes de control usados de forma individual. Las pruebas en invernadero muestran que no hay diferencia significativa entre el uso de la mezcla de quitosano y extractos de P. fluorescens y el agroquímico comercial, por lo que la mezcla podría ser una estrategia para el control de hongos fitopatógenos en cultivos hortofrutícolas.










texto en 


